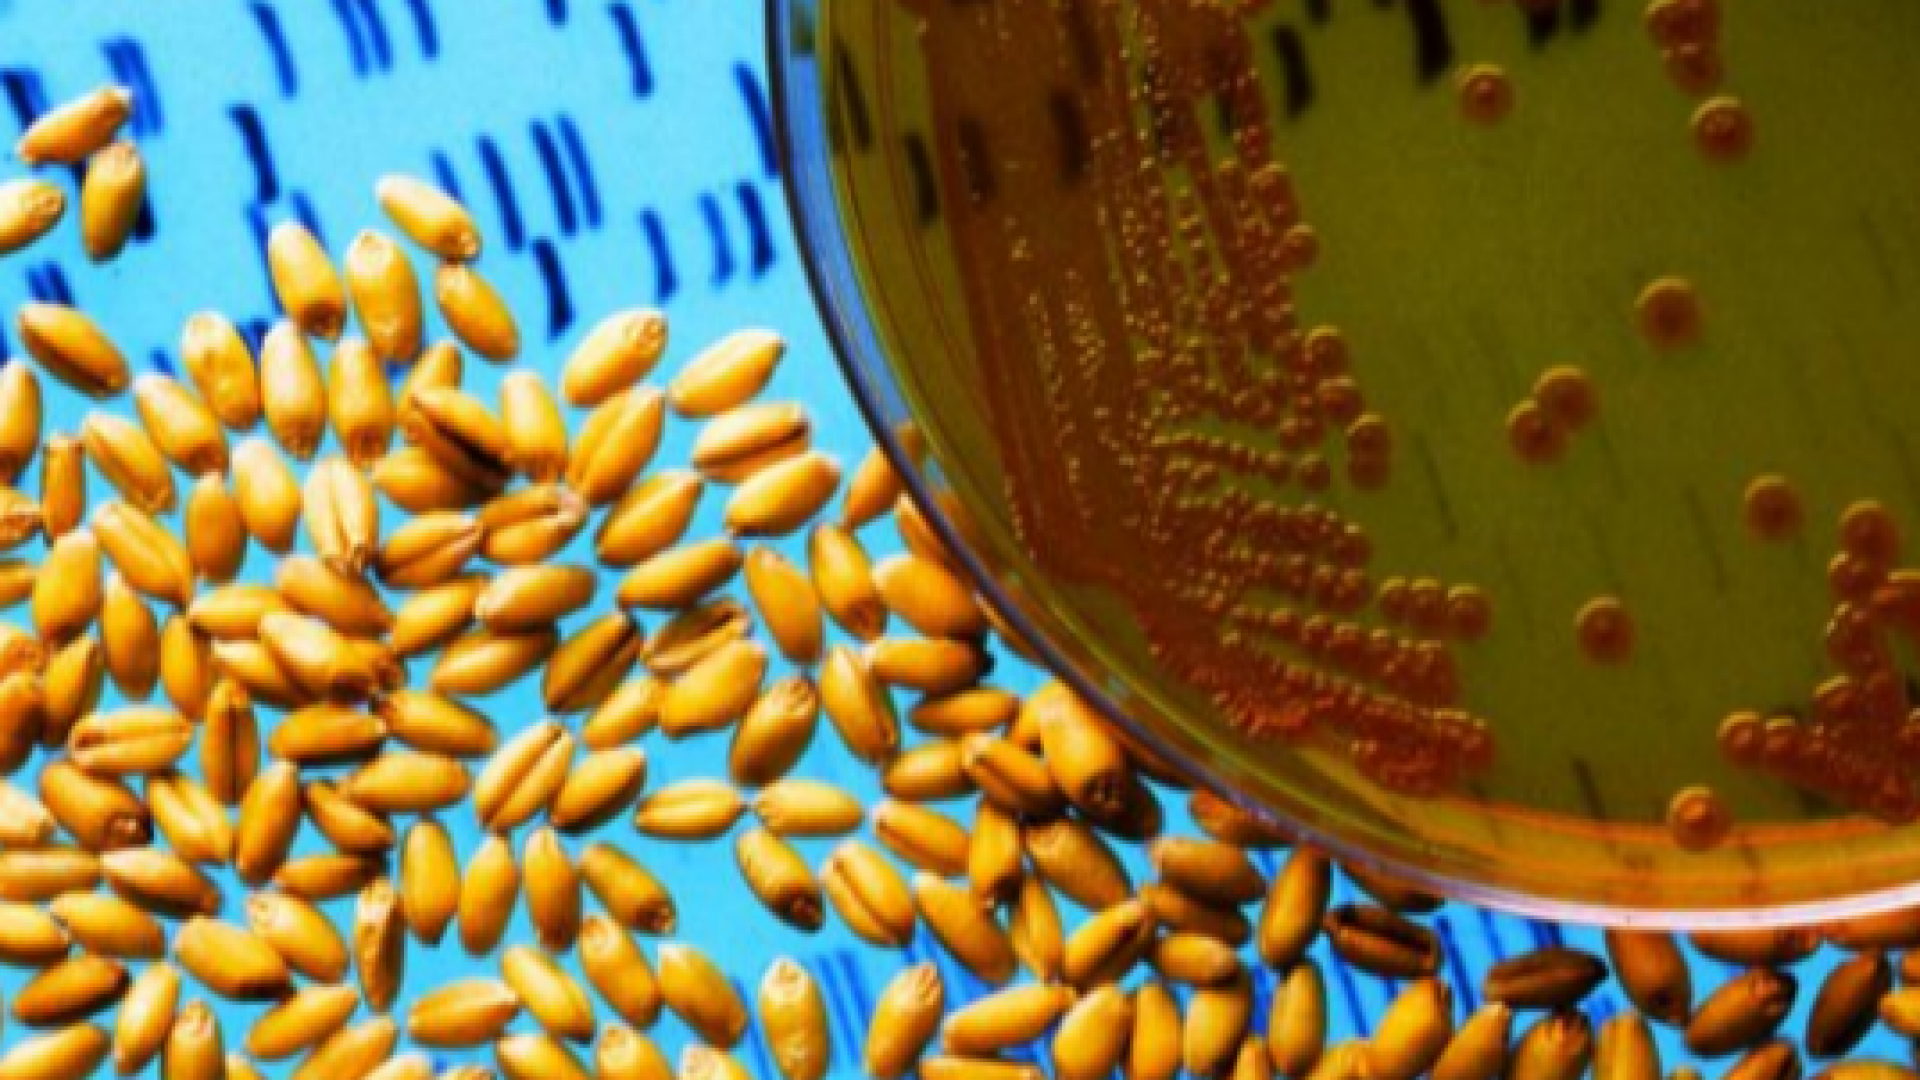
"CELLULAR AGRICULTURE - FUTURE OF FOOD"

En 2016, pour sa septième édition, Futur en Seine transforme sa programmation en manifeste : Tous hackés ? Tous hackers !
Parce que “hacker”, c’est contourner les protections logicielles et matérielles, mais aussi détourner les habitudes en places pour prendre le contrôle. Au travers de 10 temps forts, nous mettons la lumière sur la façon dont la technologie transforme non seulement nos manières de produire, de nous divertir, de faire du sport ou d’apprendre, mais aussi comment elle agit directement sur nos corps et nos cerveaux. Automatisation, dématérialisation, connexion permanente, transhumanisme… Ce ne sont plus seulement les joueurs qui changent, c’est le jeu lui même.
Face à l’inquiétude que peuvent provoquer ces bouleversements économiques, sociaux et culturels, Futur en Seine réaffirme que nous avons les outils pour (re)prendre la main sur notre futur, démoder les modèles en place et réaffirmer notre capacité d’agir et de contribuer.
En touchant à nos corps, nos sensations, notre vision et à toutes les données attachées à nos mouvements et à nos actions, ces nouvelles technologies permettent à chacun d’augmenter sa perception du réel, de doper ses capacités sensorielles, de tourner à son profit ses données et sa force de travail. Il est désormais possible de prendre le contrôle.
Pour porter cette vision, nous avons souhaité donner la parole à la jeunesse et aux entrepreneurs du changement. Nos speakers incarnent ainsi ces nouvelles voix qui proposent un futur innovant, audacieux et engagé.
"Futur en Seine, le festival du numérique, présente les objets et services de demain. C’est la vitrine de l’innovation numérique, c’est aussi un lieu de rencontres et d'affaires extrêmement fédérateur" souligne le président de Cap Digital, Stéphane Distinguin.
Le Village des Innovations dans le quartier des Arts et Métiers, dévoilera un programme tourné vers le numérique responsable, offrant à l'essai des prototypes, des robots, des nouveaux objets, des conférences pour comprendre et débattre...
-
Mentalista Guinguette
Jeudi, vendredi et samedi dans le Square Emile Chautemps (devant la Gaîté lyrique) - de 17h à 21h. Sans inscription préalable !
Par la seule force de la pensée… vous allez participer à un apéritif mémorable !
Harnaché(e) d’un OpenBCI sur la tête -objet captant les ondes électriques de votre cerveau- vos désirs de cacahuètes, de saucisson ou de chips seront exaucés par l’enchantement de vos ondes cérébrales. En lien direct avec votre cerveau, une imprimante écrira votre choix de notre menu. Et puis, enchantement parmi tous les enchantements du monde moderne vous ferez aussi léviter du saucisson par la seule force de votre pensée. De sacrés duels en perspective, car vous pourrez participer jusqu’à 4 personnes en même temps.
4 mots-clés : dada, data, chips, saucisson.
Événement organisé par We love the net et Data Dada